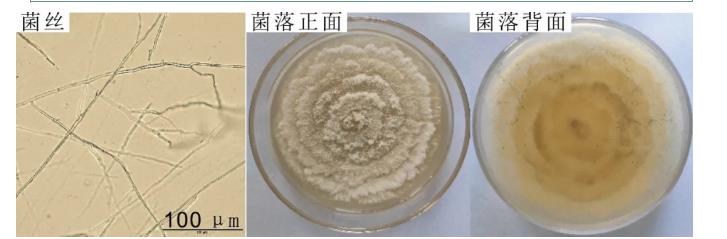
柑桔砂皮病菌座殼菌生長條件及納米藥劑篩選（一）

谷氨酰胺轉(zhuǎn)氨酶(EC 2.3.2.13,TGase)能夠催化蛋白質(zhì)發(fā)生共價交聯(lián),廣泛應(yīng)用于肉制品、乳制品和豆制品等蛋白基食品的質(zhì)構(gòu)改良,并在制藥、紡織 ...
歡迎來到BioSense網(wǎng)站!
歡迎來到BioSense網(wǎng)站!

谷氨酰胺轉(zhuǎn)氨酶(EC 2.3.2.13,TGase)能夠催化蛋白質(zhì)發(fā)生共價交聯(lián),廣泛應(yīng)用于肉制品、乳制品和豆制品等蛋白基食品的質(zhì)構(gòu)改良,并在制藥、紡織 ...

通常情況下,腸道菌群的構(gòu)成及數(shù)量保持著一種動態(tài)平衡,維持宿主的體內(nèi)穩(wěn)態(tài)。然而飲食習(xí)慣、藥物濫用和感染等會破壞這種平衡,進(jìn)而影響宿主的腸道免疫及內(nèi)分泌調(diào) ...

帕金森病是一種常見的神經(jīng)退行性疾病,嚴(yán)重威脅著中老年人的健康,然而目前帕金森病的發(fā)病機(jī)制尚不完全明確。近年的研究顯示,腸道菌群在帕金森病的發(fā)生發(fā)展中發(fā) ...

在本研究中,未能測定柑桔砂皮病菌S2菌株的產(chǎn)孢時間及產(chǎn)孢量,也未涉及納米試劑與農(nóng)藥混合使用的效果及納米試劑對農(nóng)藥藥效的影響等內(nèi)容。這有待于進(jìn)一步研究。 ...
本試驗從重慶市長壽區(qū)“愛媛38”(現(xiàn)在普遍被稱為“紅美人”)雜柑園采集典型砂皮病葉,分離純化及鑒定病原菌,研究其生物學(xué)特性,篩選對其具抑制作用的納米藥 ...

近年來,DNA甲基化標(biāo)志物已經(jīng)作為癌癥治療的靶點,而DNA甲基化抑制劑在不久的將來可能成為癌癥治療一種重要手段。研究DNA甲基化在生長抑制中的機(jī)制,將 ...

DNA甲基化與許多疾病的發(fā)生、發(fā)展密切相關(guān)。近年來發(fā)現(xiàn),DNA的異常甲基化與生長抑制有關(guān),如胚胎的生長發(fā)育,病變細(xì)胞如腫瘤細(xì)胞的生長抑制。此外,外界刺 ...

目的:評估細(xì)菌超聲分散計數(shù)儀(簡稱“細(xì)菌計數(shù)儀”)在結(jié)核分枝桿菌藥物敏感性試驗(簡稱“藥敏試驗”)中的生物安全優(yōu)勢。方法:使用細(xì)菌計數(shù)儀和磨菌瓶兩種方 ...

本文通過對體檢人群中單核細(xì)胞計數(shù)增多的影響因素分析,發(fā)現(xiàn)受檢人員體質(zhì)量增加,血脂異常增高以及血尿酸增高與單核細(xì)胞計數(shù)增多有一定的相關(guān)性,分析的結(jié)果和上 ...

本試驗選擇自主合作研發(fā)的全自動菌落計數(shù)儀,對平皿上的菌落進(jìn)行計數(shù),與人工肉眼計數(shù)結(jié)果進(jìn)行比較,以驗證全自動菌落計數(shù)儀的準(zhǔn)確性、精密度和重現(xiàn)性,從而確定 ...